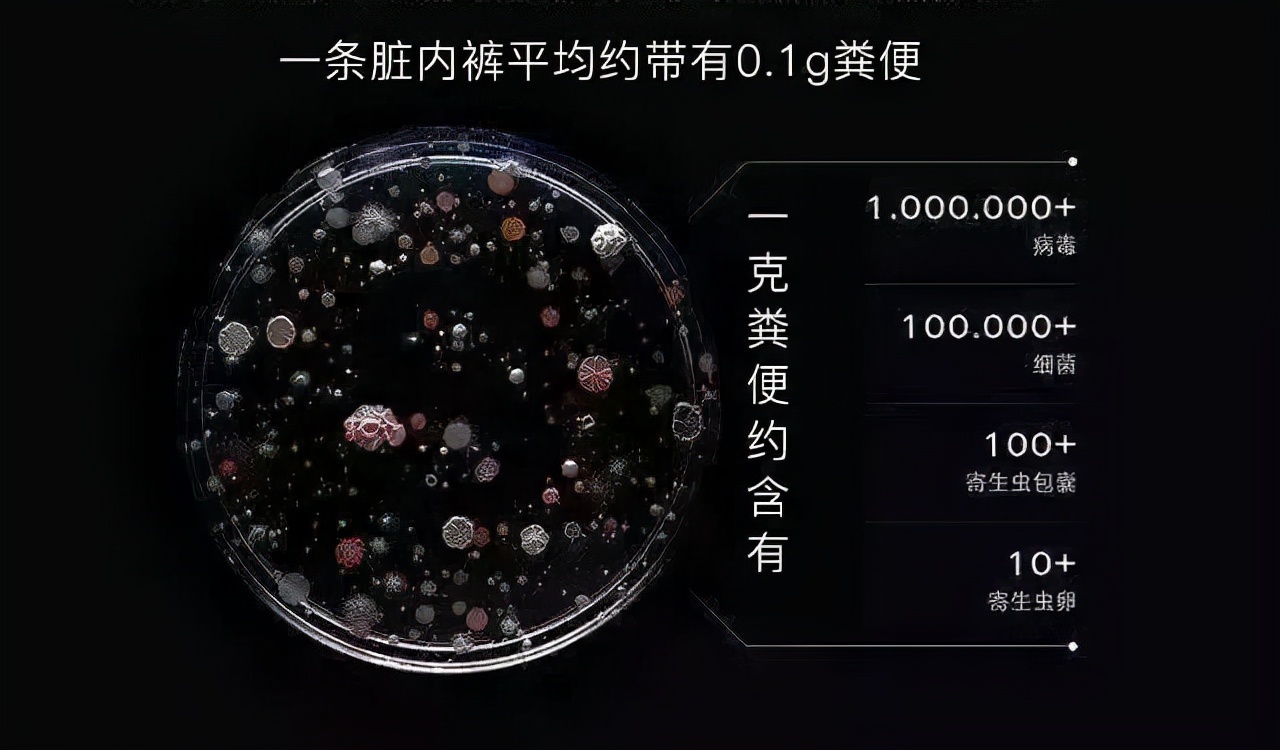
男士内裤要勤更换不然就很脏,男士内穿裤多久更换一次

有些男人表面光鲜亮丽,但*裤内**却破得像抹布!
从前任到现任,从旧爱到新欢。
流水的感情,铁打的*裤内**,亲身演绎“陪伴是最长情的告白”。
男人为什么不爱换*裤内**?

鞋子天天买,但*裤内**永流传。
即便是再爱挥霍的男人,在*裤内**上也会“抠”得惊人。
有数据统计,全球男性*裤内**平均是每6年换一次,即便穿得“质壁分离”都舍不得扔。
据部分男士透露,穿久了的*裤内**会自带记忆功能,更能达到“人裤合一”的境界。在套上的瞬间,*处私**就自动进入舒适环境。丁丁、蛋蛋找好位置,不会卡档、不会被夹,如无物一般轻盈舒爽。
男人这么重视*裤内**的松紧不是没道理,因为不适合的“居住环境”还会影响下一代!
2018 年哈佛大学曾对656名寻求过不孕症治疗的男性进行过调查,让他们在同一天提供了精液样本和血液样本并汇报自己的*裤内**偏好。

结果显示,和喜欢穿紧身*裤内**的男生相比,偏爱宽松短裤的男生精子浓度高出25%,精子数量高出17%,精子活力更是高出33%。
但是,兄弟们,这并不意味着*裤内**经常不换是件好事。
*裤内**应该多久换一次?

*裤内**紧贴着生殖器和排泄器官,难免会沾上一些自身的分泌物和排泄物。
一条穿过的脏*裤内**平均会存在0.1克的粪便,里面包含各种各样的细菌、病毒和寄生虫卵。
除了粪便之外,还有尿液、前列腺液等分泌物沾上的*裤内**,可以说是所有衣物中最脏的。
而且这些脏东西不能完全通过简单的洗涤清除,一旦长期和*处私**亲密接触,还容易引起瘙痒、湿疹、股藓,甚至前列腺炎、*丸睾**炎等等疾病,这些毛病不同样可能导致男性不育吗?
而且最糟心的是,不少伴侣也要为你的“挚爱*裤内**”买单,很多女性妇科病其实是男性带来的,由于丁丁周围皮脂腺、汗腺丰富,包皮包茎很容易藏污纳垢,再加上不爱更换*裤内**的“节俭”习惯,*处私**的卫生情况可见一斑。
所以建议男性朋友:*裤内**穿半年,就该扔了换新的。如果已经着色或变形,哪怕没到更换时间也不能穿了,因为这会影响*裤内**的吸湿效果和透气性。
再穷不能穷*裤内**,不要因为讨厌磨合,而委屈了“小兄弟”。
男人如何选一条“五星级”*裤内**?

*裤内**对男性的重要性更是不言而喻。
差劲的*裤内**,会让“兄弟”无法自动伸缩难以透气,自身温度就会升高,从而使精子坏死、存活率下降。
所以*裤内**作为贴身衣物,选购上才更应加注意,挑一条好*裤内**,还是很有讲究的。
首先,优先选择透气、排汗吸湿效果好的面料,纯棉、莫代尔、竹纤维等面料就是不错的选择!
其次,一定要选尺码合身。太紧、太小,会让*裤内**透气变差,更容易造成精子细胞发育不良、活力过差等问题。
然后,少选深色*裤内**。颜色越深的*裤内**,就说明越是有染色剂的成分,所以选择浅色的*裤内**,才更亲肤,更健康!
最后,推荐选*裤内**前有个兜兜的款式。这种设计是专门用来放置阴囊的,可以防止阴囊下垂,减少与*裤内**的摩擦,增加透气性,更加符合男士生理结构的需求。
所以汉子们,快把你家的陈年*裤内**换了吧,人家工作这么多年也该下岗了!
【参考资料】
1.*裤内**应该几天一换洗?穿多久就要丢掉?这 4 点你要知道.丁香医生 .2022-02-20
2.男生的*裤内**,为啥这么容易破?.病理青年. 2022-02-16
3.男生*裤内**前面的兜是干嘛用的?.杜小雨. 2021-10-10